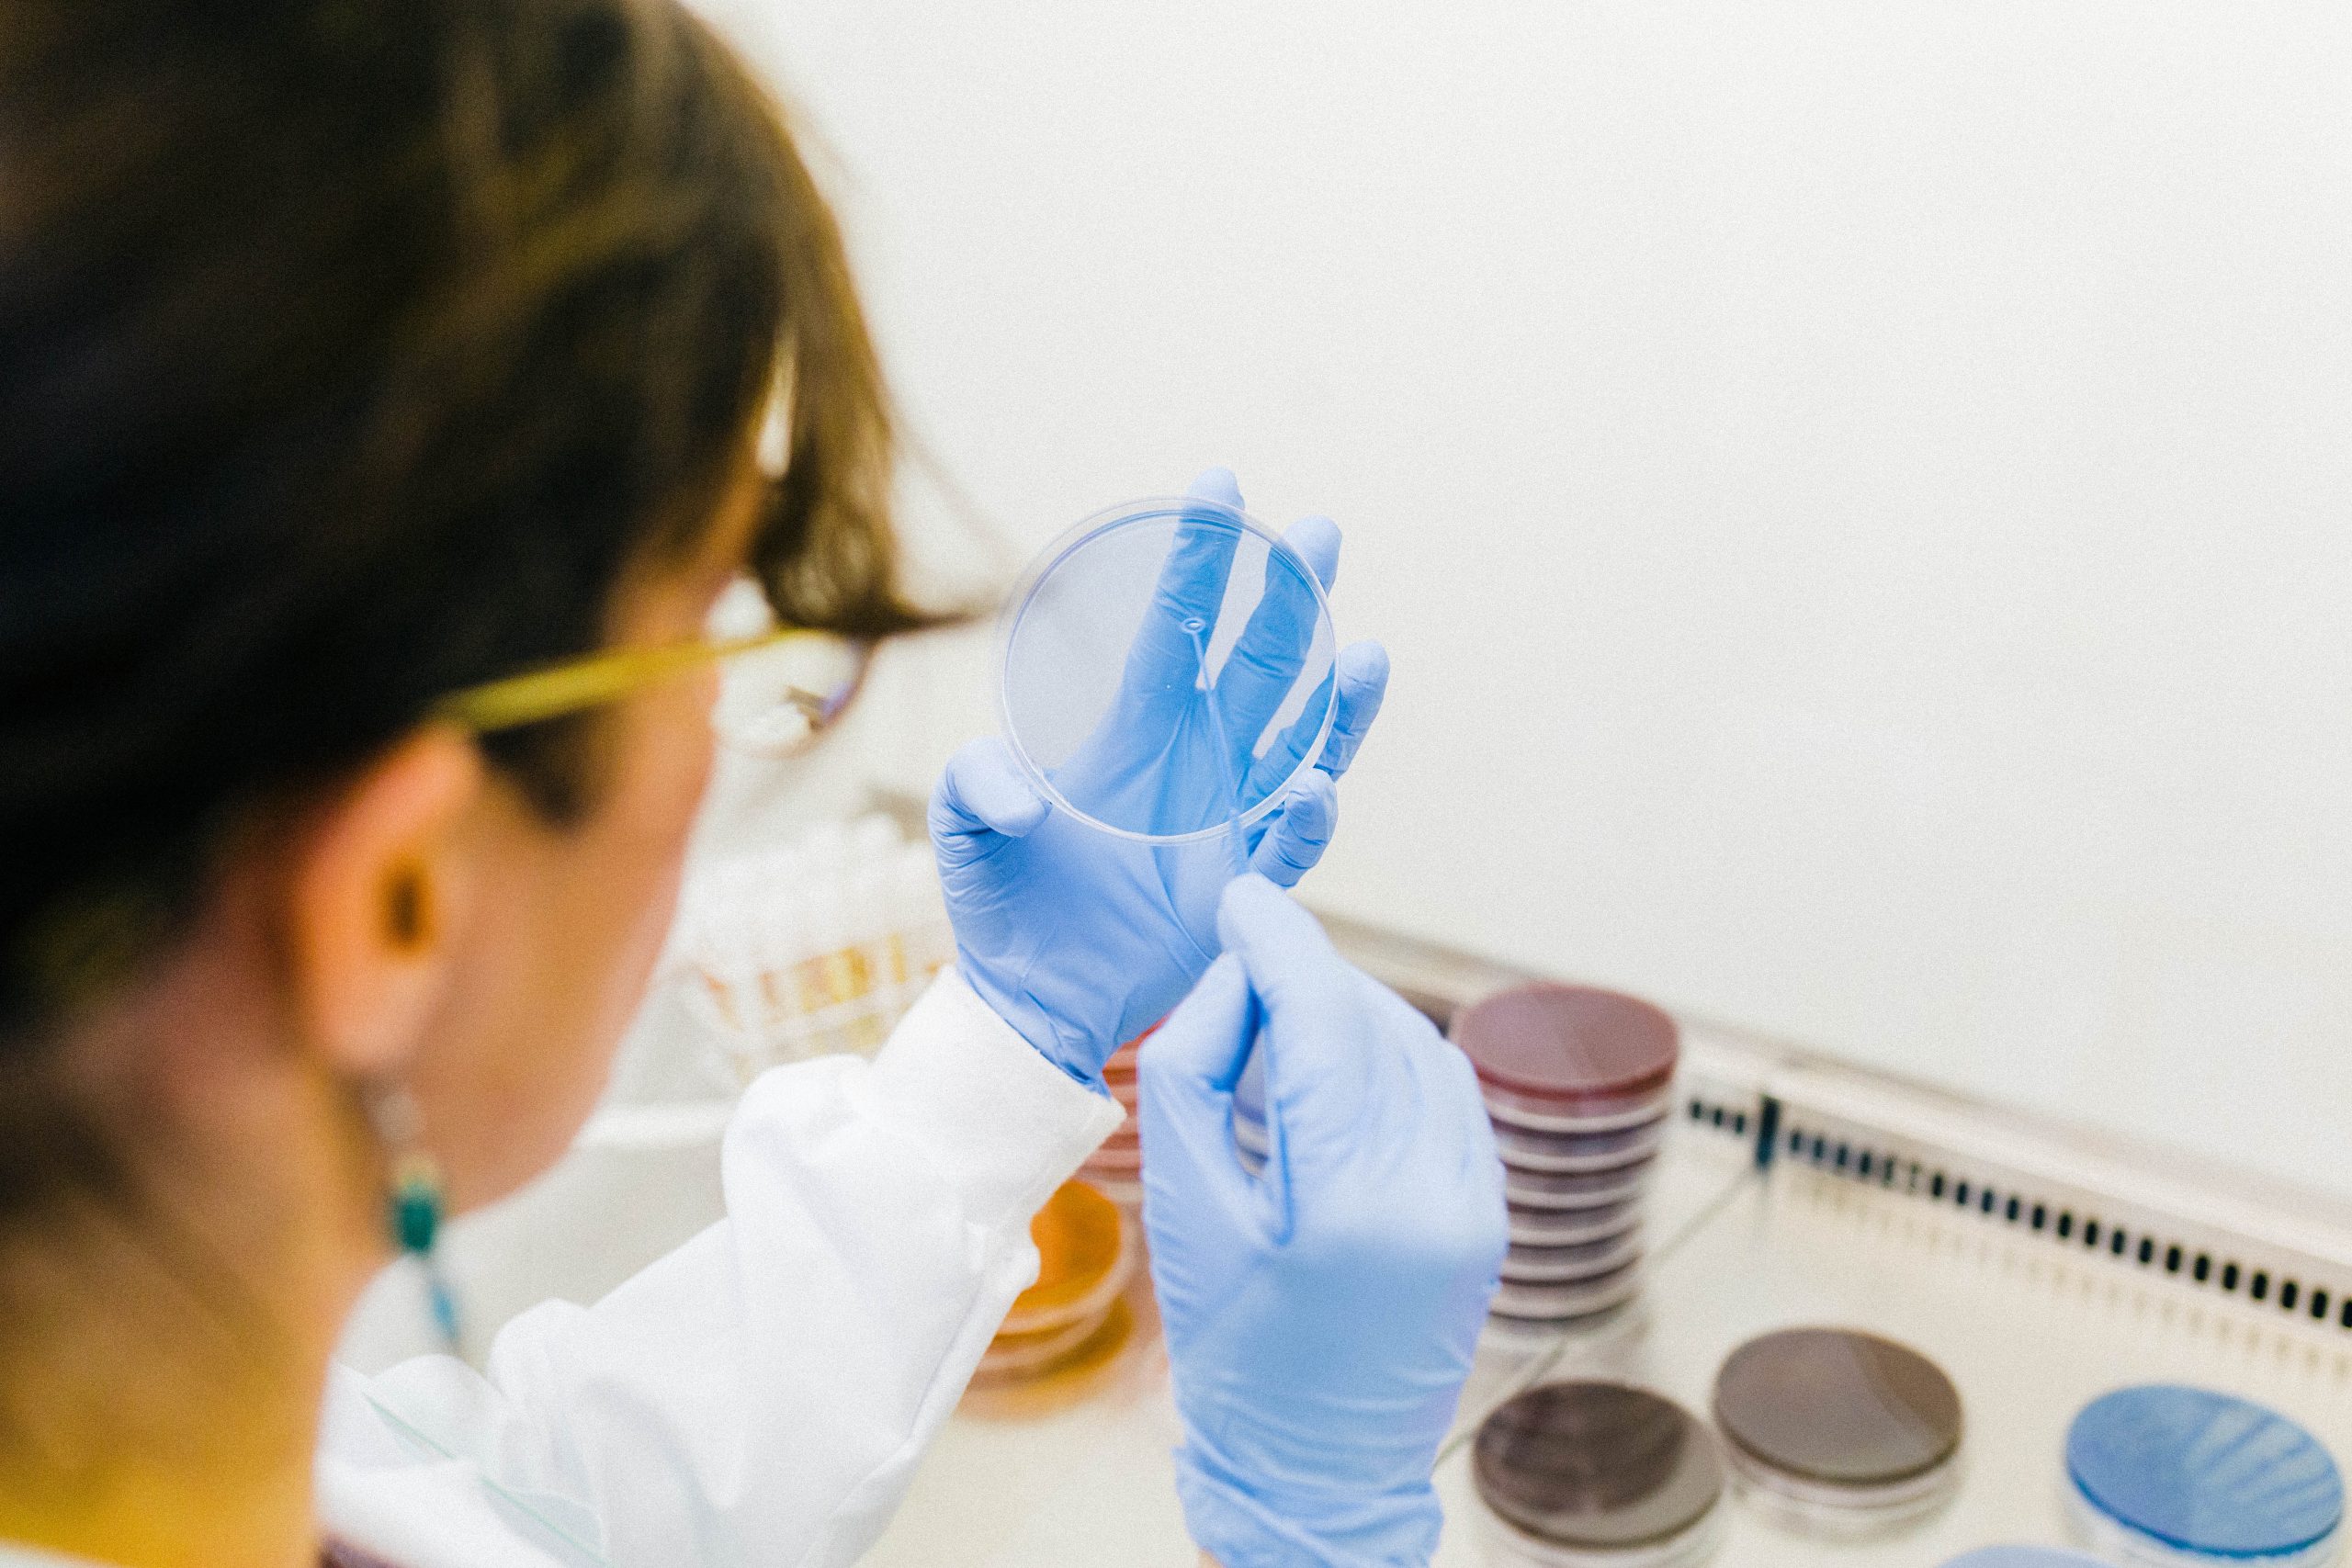
microviable_2023-99-1-scaled

SEED Biosciences – DISPENCELL-TITER


SEED Biosciences ha desarrollado DISPENCELL-TITER, un avanzado sistema de pipeteo basado en impedancia que promete transformar el desarrollo de líneas celulares destinadas a la bioterapia. Esta innovadora plataforma permite el aislamiento de células individuales y la predicción inmediata de los mejores productores, reduciendo drásticamente el tiempo y los costos necesarios para identificar clones celulares de alta productividad.
Con DISPENCELL-TITER, las empresas pueden detectar las “células doradas” desde el día 0, acortando el tiempo de selección hasta en 6 semanas y reduciendo los costos hasta en un 90%.
La propuesta de valor de la plataforma incluye un manejo delicado de las células, lo que garantiza una alta eficiencia en la clonación, además de un diseño compacto y fácil de usar que se integra perfectamente en los flujos de trabajo actuales para el desarrollo de líneas celulares. Sus aplicaciones abarcan la producción de proteínas recombinantes, el descubrimiento de anticuerpos monoclonales e incluso el desarrollo de carne cultivada, y abordan necesidades críticas de la industria. Además, contribuye a los objetivos de sostenibilidad global al reducir el desperdicio y el consumo de energía en los procesos de cultivo celular.
La innovación de SEED Biosciences está destinada a convertirse en un nuevo estándar en la fabricación de bioterapéuticos, mejorando significativamente la productividad y la escalabilidad. Para 2028, la empresa aspira a generar ingresos significativos y a crear empleos altamente calificados en Suiza y a nivel internacional.
Gracias al competitivo programa , SEED Biosciences ha asegurado 2,6 millones de francos suizos en financiamiento. Esta inversión acelerará la industrialización y el lanzamiento al mercado de DISPENCELL-TITER, posicionando a la empresa como líder global en tecnología para el desarrollo de líneas celulares.